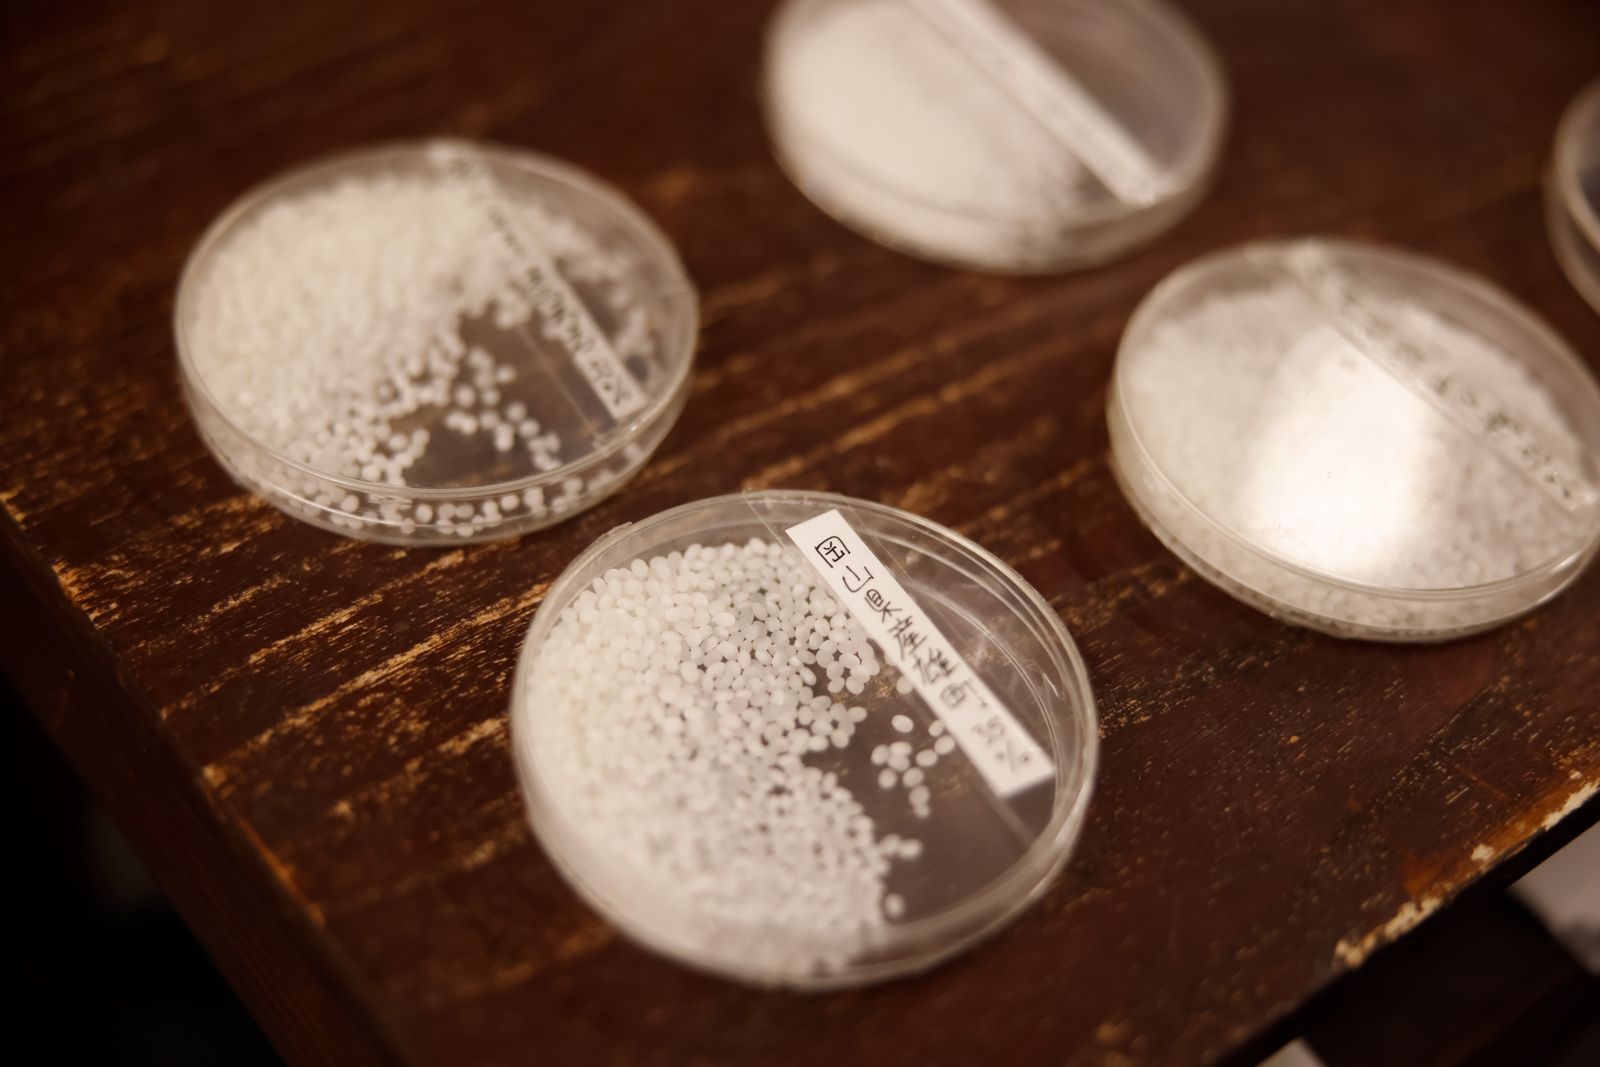
09_LR57377

お酒
和光の庭崎紀代子社長、富山に「IWA 5」の酒造を訪ねる。
羨望の日本酒は、どのように仕込まれているのか!?
2025.12.29

「Amazing」。 英語で「予想を上回る驚きのある素晴らしさ」を表現する言葉。これをテーマにしているのが銀座「和光」だ。時計や宝飾品はもちろん、ファッションからアート、フードまで「和光」ならではの審美眼で選び抜かれた上質なものを揃えている。クラシカルな建物に一歩足を踏み入れれば、その空間はエレガンスと、きめ細やかなホスピタリティーに満ちている。
2025年秋。「和光アネックス」のティーサロンに、‟日本酒「IWA 5」×和光が誇るショコラ・フレ”のマリアージュが登場した。日本酒とショコラという、常識を覆す組み合わせ。しかも日本酒は、近年日本酒愛好家の間で驚きと羨望を持って語られている「IWA 5」だ。
「和光」は2022年、建物を「セイコーハウス」に、お店を「和光本店」に名称を変えた。「和光を世界ブランドに」と舵を切ったのが、当時セイコーホールディングス(株)(現・セイコーグループ(株))常務取締役でコーポレートブランディング担当だった、現・代表取締役社長・庭崎紀代子。この「日本酒とショコラ・フレ」プロジェクトを牽引したのも庭崎氏だ。「IWA 5」を造る富山の酒蔵へも以前、足を運んでいる。今回、酒の仕込みが始まると聞き、庭崎氏は早速、酒蔵を再訪した。

ふくよかな曲線を描くような芳醇な味わい、山々から森の樹々へそよぐ風を思わせるようなピュアな香り。さまざまな味のイメージが余韻とともに顔をのぞかせる。そんな複雑さを併せ持つ「IWA 5」。手掛けたのはシャンパーニュの最高峰と謳われる「ドン ペリニヨン」の醸造最高責任者を28年務めたリシャール・ジョフロワ氏。日本と日本酒に魅せられたジョフロワ氏は、これからの人生を日本酒に賭けたいと2019年には富山県白岩に会社を設立。シャンパーニュのアッサンブラージュ(ブレンド)の技を用いた独創的な日本酒造りに着手し、2021年には酒蔵が完成した。
「IWA 5」の「5」は、酒米の品種、産地、酵母、酛造りの手法、発酵方法といった日本酒を構成する5つの要素に由来する。さらに5という数字は、バランス、ハーモニーや融合、本質を表す、アッサンブラージュを象徴する数字だ。日本酒はもともと、単一の酒米と単一の酵母で醸造し、それを瓶詰めして出荷することが一般的だった。一方、「IWA 5」は、酒米の品種を「山田錦」「雄町」「五百万石」の3種に絞り、これら異なる産地の3種類の酒米を全て35%まで精米し、5種類の酵母を使ってそれぞれ仕込み、毎年、17種類ほどの原酒が出来上がる。これに、その年以前までに造られたリザーブ酒を加え、全50種類ほどがアッサンブラージュ候補の原酒となる。この手間暇を考えると気が遠くなるが、全てはジョフロワ氏がアッサンブラージュする1作品のために造られるのだ。
JR富山駅から車を40分ほど走らせれば、3,000メートル級の山々が連なる立山連峰の麓、立山町白岩に到着する。森と田んぼに囲まれたのどかなエリアにモダンな蔵が見えてきた。ジョフロワ氏の長年の友人で、日本を代表する建築家・隈研吾氏の設計だ。
迎えてくれたのは、「IWA 5」を造る株式会社 白岩のシャルル・アントワン・ピカール社長。「リシャール・ジョフロワは、いつも言っています。ワインにはテロワール(風土)が最も大切だが、日本酒造りにおいて一番重要なのは、造り手と蔵だと。だからでしょう、蔵の場所の選定から設計まで、隈さんにじっくり付き合っていただきました」。


神の宿る山と言われる立山連峰を背景に、富山湾までが視界に入る絶好のロケーション。茅葺き屋根を連想させる大きな屋根の蔵。この一枚屋根の蔵のアイディアは、ひとつ屋根の下で囲炉裏を囲み、家族や仕事仲間、家畜たちもが生活を共にする富山・五箇山の合掌造りの農家にインスピレーションを得た。酒造りの場所、ゲストを迎えるレセプションルーム、関係者用の宿泊施設まであるのが蔵の理想だというジョフロワ氏の強い思いから、このスタイルになったのだという。
全面ガラス張りのレセプションルームは「土間」と呼ばれ、囲炉裏が誂えられている。試飲会や食事会もここで開かれる。奥にずらりとステンレスタンクが並んだ光景は壮観のひとこと。ここまで開放的な蔵は日本随一だろう。蔵人も自然の風景を見ながら仕事ができ、心のストレスも軽減されるはず。酒蔵建設前の田んぼの籾殻が練り込まれた、富山の伝統工芸品「五箇山和紙」が壁にあしらわれている。五箇山の和紙職人が一枚一枚漉き上げ、1万枚ほども施されている様子は圧巻である。

酒蔵のホスピタリティマネジャー、マチユ・グラセ氏から酒蔵の説明を受ける。酒母に麹、蒸米、水を加えて発酵させていく「もろみ仕込み」のタンクをのぞく。でんぷんが糖に、糖がアルコールになっていくのに3〜4週間かかる。「プチプチ元気!こちらのタンクからはお酒の芳醇な香りが立ち昇ってきます。麹が生きていますね」と庭崎氏。
ここで、日本酒造りの工程をざっとご説明しよう。
<原料>
酒米、水、米麹、酵母の4つ
<工程>
①米を精米→洗米→水に浸す→蒸す(蒸米)。
蒸米は、麹造り、酒母、もろみの仕込みに使われる。
②麹づくり
蒸米に麹菌を繁殖させ、温度と湿度を管理しつつ菌を育て、麹をつくる。麹は酒母、もろみに加え米のでんぷんを糖化する役割を果たす。
③酒母(酛)づくり
蒸米、麹、水に酵母を加えたもの。“発酵の土台”、文字通り「酒の母」になる。
④もろみ仕込み(発酵)
酒母に、蒸米、米麹、水を3回に分けて加える(三段仕込み)。日本酒造りの特徴。雑菌の繁殖を抑えつつ酵母の繁殖を促し、もろみの温度管理をする。ここで日本酒独特の並行複発酵(糖化とアルコール発酵が並行して進行)が行われる。
⑤上槽、ろ過、加熱、貯蔵、瓶詰め
3週間ほどで発酵が終われば、搾って酒と酒粕に分ける。搾りたての新酒は火入れや熟成、瓶詰めという工程を経て出荷。火入れを一切しなかったり、ろ過をしなかったりすることも。
(IWA 5は上槽後、一旦貯蔵タンクで保管される。ジョフロワ氏により原酒のアッサンブラージュ比率決定の後、ブレンド、瓶詰めを行い、最低でも16カ月の熟成期間を経て出荷される。)
ひとことで言えば、米を糖に変え、糖をアルコールに変えることを同時に行うのが日本酒造り。精米から並行複発酵、段仕込みというとても複雑な工程を経て、約60日間をかけ、日本酒は誕生する。
「IWA 5」は山田錦、雄町、五百万石の3種類の酒米を産地別に仕込む。精米歩合は35%。米の表面の65%を削っているということになる。吟醸酒では精米歩合60%、大吟醸酒は50%以下と決められている。よって「IWA 5」は大吟醸酒の部類に分けられる。
早朝6時半。杜氏の藪田眞人氏と蔵人12人によるチームはすでに集合し、米を蒸し始めていた。藪田氏は以前、老舗酒蔵「剣菱」を率いた名杜氏。伝統を守りながら、ジョフロワ氏の要望にも応え、最新の技術の導入にも余念がない。この日は米を蒸し、麹をつくり、もろみの仕込みをする。17種類もの酒を仕込むが、これは全てアッサンブラージュの種酒となり、全てはIWA 5のために醸され、毎年IWA 5の新たなひと作品が発売される。種酒はリザーブ酒としても熟成され、次の年からのアッサンブラージュにも使われる。

酒蔵の朝は早い。6時半には仕事開始。

蒸米工程。蒸し時間や蒸し上がり具合が酒の味わいや香りを大きく左右する。 
蒸し上がった米は、蒸米として、また麹菌を繁殖させることで、麹として酒母になり、もろみにもなる。

蒸し上がった米をちょっと試食。「蒸したお米をいただくのは初めて! うま味がありますね」と庭崎氏。 




酒蔵見学を楽しんだ庭崎氏。「伝統を大切にしながら、革新的な造り方をされている日本酒ですね。『和光』が日本の価値を体験できる場所として、このお酒をご紹介できるのはとても意味のあることだと確信しました」。
後編では、庭崎氏とピカール氏が、「和光」のチョコレートと「IWA 5」のお酒のマリアージュについて語り合う。

2025年10月1日にリリースされたのが「IWA 5 アッサンブラージュ6」。リシャール・ジョフロワの卓越したアッサンブラージュの技と、名杜氏による伝統と革新の醸造の技、富山の豊かな自然によって完成された。6作品目のリリースは、ひとつの到達点を迎えたのだという。本質を守り抜くために余分を削ぎ落とし、揺るぎない1本の線を伸ばし続けた、精緻追求の賜物だ。新たな未来への扉が開かれた「IWA 5」の1本。720ml 1万6500円

和光アネックス
住所/東京都中央区銀座4-4-8
TEL/03-3563-9701
https://www.wako.co.jp/
2階のティーサロンで、「IWA 5」、および「ショコラ・フレ」のセットを提供。
IWA 5 アッサンブラージュ 6(2024) 1杯(90ml)3300円
IWA 5 アッサンブラージュ 2(2020) 1杯(90ml)4400円
IWA 5 アッサンブラージュ 6(2024)& 2(2020) 各1杯(45ml)3850円
ショコラ・フレとのマリアージュセットは、
IWA 5 アッサンブラージュ 6には「ジャンジャンブル」
IWA 5 アッサンブラージュ 2には「グアナラ」を提供。各プラス605円
飲み比べセットには、「ジャンジャンブル」「グアナラ」を提供。プラス1210円
地階のグルメサロンで「IWA 5」をボトルでも販売中。
※数量限定のため、売り切れる場合があります。
Photograph:Hiroyuki Matsuzaki(INTO THE LIGHT)
Text:Mika Kitamura

![株式会社星野リゾート<br>代表 星野佳路 インタビュー[後編]<br>[ニッポンの社長、イマを斬る。]](http://p.potaufeu.asahi.com/c486-p/picture/31018807/fa755b168c94b3bebfcbe3c570d0040a_640px.jpg)








